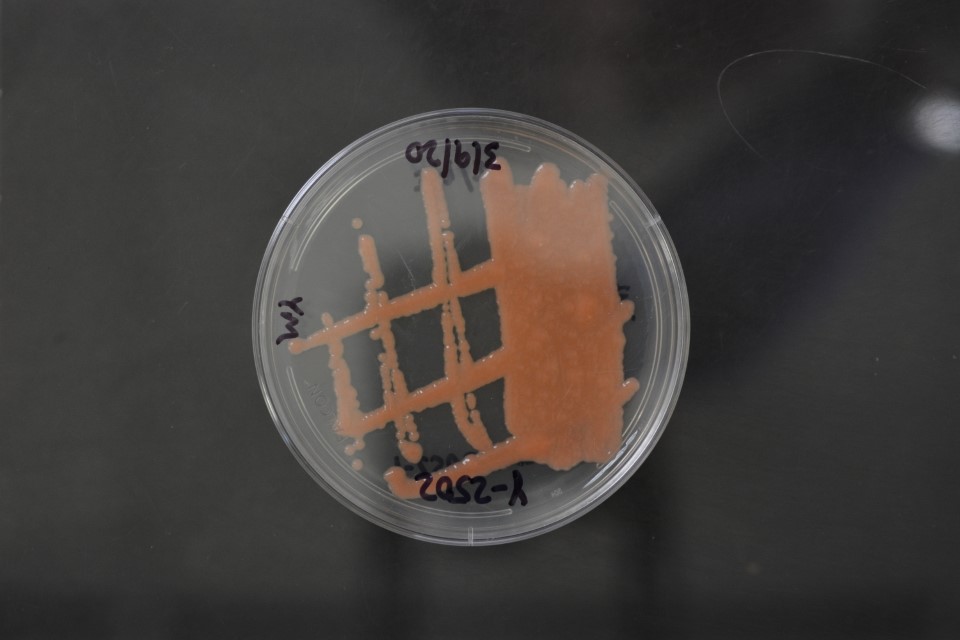

Rhodotorula glutinis
NRRL Y-2502(Type Strain)
Accession numbers in other collections:ATCC 2527=CBS 20=IAM 14113=IFO 1125=IGC 4177=JCM 8208=UCD-FST 68-255
Source:CBS,Delft,The Netherlands
Isolated from(substrate):AIR
Substrate location:Berlin,Germany
Genetic info:GenBank:D1/D2(AF070430),ITS(AF444539).
Growth media:Yeast Extract-Malt Extract-Peptone-Glucose(YM for yeasts)(number 6)
Optimum growth temperature:25C
Strain images:
NRRL_Y-2502_6.JPG